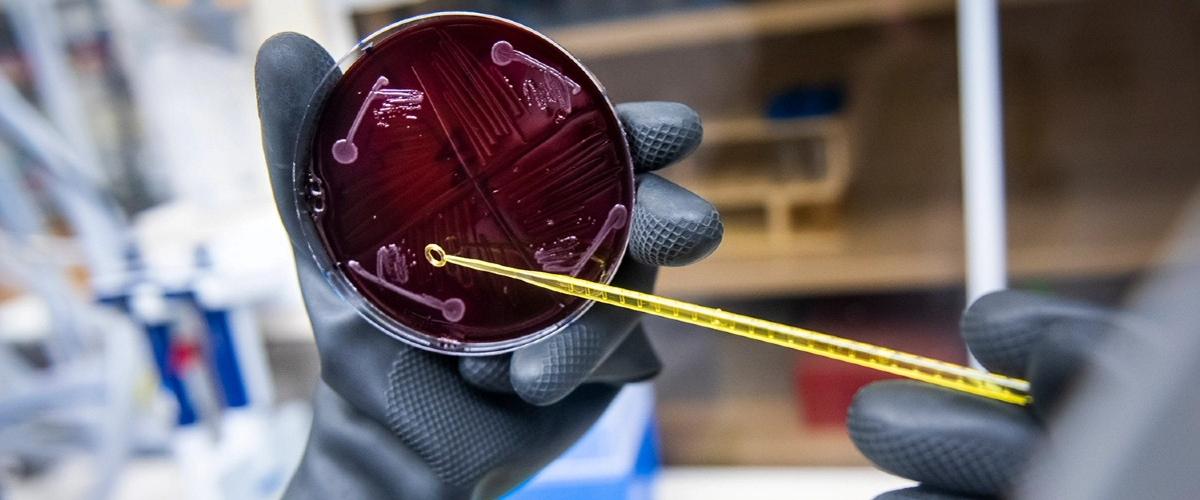
TODO:

Влияние бактерий кишечника на здоровье человека неоспоримо. Ряд исследований подтверждают, что изменение микробиоты и развитие многих заболеваний имеют причинно-следственную связь. Учитывая растущий интерес ученых по всему миру к теме изучения микробиоты, исследователи из Стэнфордского университета создали в лаборатории наиболее сложную модель, состоящую из более чем 100 видов бактерий.
«Сообщества этих бактерий сложны и без систематических способов изучения их составляющих точные клетки и молекулы, связанные с определенными заболеваниями, остаются загадкой», — объясняют авторы.
Теперь у них появляется возможность добавлять, удалять и редактировать отдельные виды бактерий, чтобы лучше изучить пути, связанные с заболеваниями.
Модель микроботы, названную hCom1, создали с нуля, выращивая по отдельности каждый вид бактерий, а затем смешивая их в единое сообщество. На примере моделей стерильных мышей ученые продемонстрировали, что после трансплантации 98% бактерий были стабильны в кишечнике грызунов.
Затем было показано, что микробиота защищала животных от инфицирования кишечной палочкой, что указывает на функциональность созданной модели.
Полученные результаты открывают огромные возможности для изучения влияния бактерий кишечника на здоровье человека. Это особенно важно на фоне результатов исследований последних лет — ученые все чаще находят подтверждения, что состав бактерий кишечника может определять или влиять на развитие ревматоидного артрита, рассеянного склероза, болезней мозга, сердечно-сосудистых заболеваний, депрессии и многих других. По их мнению, изучение микробиоты кишечника произведет революцию в медицине завтрашнего дня.